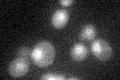
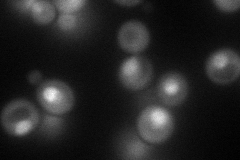
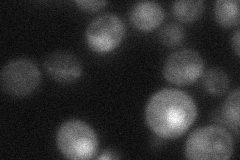
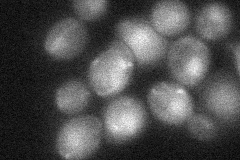
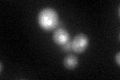

View description
UBX (ubiquitin regulatory X) domain-containing protein that interacts with Cdc48p
Localization:
Intensity:
Fold change:
Significance:
-
C’ GFP library in SD
nucleus25.25 -
N' NOP1pr-GFP in SD
cytosol,nucleus96.2167 -
N' TEF2pr-mCherry in SD

nucleus176.746 -
N' NATIVEpr-GFP in SD
nucleus23.4134 -
N' TEF2pr-VC and Cyto-VN in SD
nucleus35.6449 -
C’ GFP library in SD+DTT
nucleus35.971.42Yes -
C’ GFP library in SD+H2O2

nucleus27.141.07No -
C’ GFP library in Starvation Media

nucleus26.721.05No -
C’ GFP library on the background of Pup2-DaMP

nucleus -
C’ GFP library on the background of CCT mutant

nucleus26.11011.03378No
